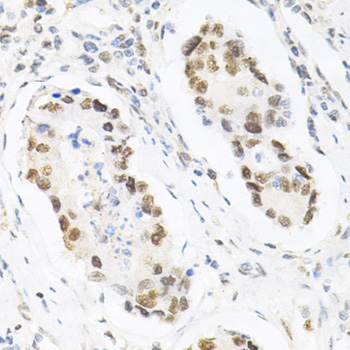
Immunohistochemistry - KPNA4 Polyclonal Antibody

-
Product Name
KPNA4 Polyclonal Antibody
- Documents
-
Description
Polyclonal antibody to KPNA4
-
Tested applications
WB, IHC, IF
-
Species reactivity
Human, Mouse, Rat
-
Alternative names
KPNA4 antibody; IPOA3 antibody; QIP1 antibody; SRP3 antibody; importin subunit alpha-3 antibody
-
Isotype
Rabbit IgG
-
Preparation
Antigen: Recombinant fusion protein containing a sequence corresponding to amino acids 1-240 of human KPNA4 (NP_002259.1).
-
Clonality
Polyclonal
-
Formulation
PBS with 0.02% sodium azide, 50% glycerol, pH7.3.
-
Storage instructions
Store at -20℃. Avoid freeze / thaw cycles.
-
Applications
WB 1:500 - 1:2000
IHC 1:50 - 1:200
IF 1:50 - 1:200 -
Validations

Western blot - KPNA4 Polyclonal Antibody
Western blot analysis of extracts of various cell lines, using KPNA4 antibody at 1:1000 dilution.Secondary antibody: HRP Goat Anti-Rabbit IgG (H+L) at 1:10000 dilution.Lysates/proteins: 25ug per lane.Blocking buffer: 3% nonfat dry milk in TBST.

Immunohistochemistry - KPNA4 Polyclonal Antibody
Immunohistochemistry of paraffin-embedded rat brain using KPNA4 Antibody at dilution of 1:200 (40x lens).

Immunohistochemistry - KPNA4 Polyclonal Antibody
Immunohistochemistry of paraffin-embedded human esophageal cancer using KPNA4 Antibody at dilution of 1:200 (40x lens).

Immunohistochemistry - KPNA4 Polyclonal Antibody
Immunohistochemistry of paraffin-embedded human stomach using KPNA4 Antibody at dilution of 1:200 (40x lens).

Immunohistochemistry - KPNA4 Polyclonal Antibody
Immunohistochemistry of paraffin-embedded human colon using KPNA4 Antibody at dilution of 1:100 (40x lens).
Immunohistochemistry - KPNA4 Polyclonal Antibody
Immunohistochemistry of paraffin-embedded human esophagus using KPNA4 Antibody at dilution of 1:100 (40x lens).

Immunohistochemistry - KPNA4 Polyclonal Antibody
Immunohistochemistry of paraffin-embedded human gastric cancer using KPNA4 Antibody at dilution of 1:100 (40x lens).
-
Background
Functions in nuclear protein import as an adapter protein for nuclear receptor KPNB1. Binds specifically and directly to substrates containing either a simple or bipartite NLS motif. Docking of the importin/substrate complex to the nuclear pore complex (NPC) is mediated by KPNB1 through binding to nucleoporin FxFG repeats and the complex is subsequently translocated through the pore by an energy requiring, Ran-dependent mechanism. At the nucleoplasmic side of the NPC, Ran binds to importin-beta and the three components separate and importin-alpha and -beta are re-exported from the nucleus to the cytoplasm where GTP hydrolysis releases Ran from importin. The directionality of nuclear import is thought to be conferred by an asymmetric distribution of the GTP- and GDP-bound forms of Ran between the cytoplasm and nucleus. In vitro, mediates the nuclear import of human cytomegalovirus UL84 by recognizing a non-classical NLS. In vitro, mediates the nuclear import of human cytomegalovirus UL84 by recognizing a non-classical NLS.
Related Products / Services
Please note: All products are "FOR RESEARCH USE ONLY AND ARE NOT INTENDED FOR DIAGNOSTIC OR THERAPEUTIC USE"
